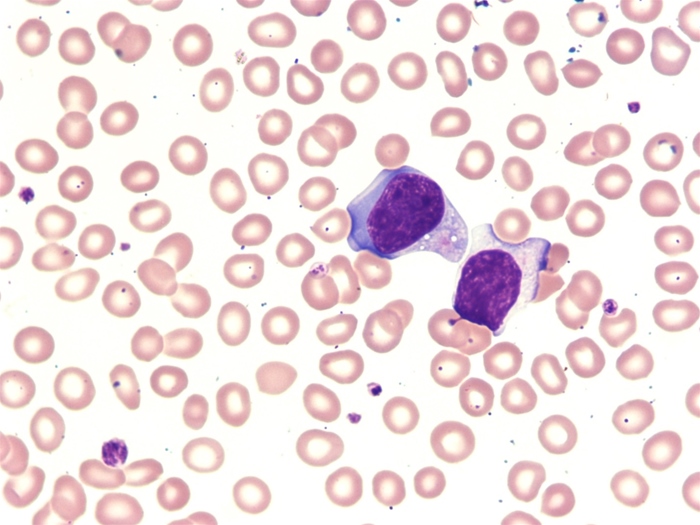
A 15-year-old boy is brought to the office due to fever.  He has had fever, chills, fatigue, and myalgias for the past 10 days.  He has lost some weight, which was attributed to poor appetite.  Three weeks ago, the patient and his family returned from a trip to the Dominican Republic; he has not traveled anywhere else.  There are no sick contacts at home.  The patient has no significant medical history and takes no medications.  Temperature is 38.3 C (101 F) , blood pressure is 110/60 mm Hg, and pulse is 108/min.  Physical examination shows a tired-looking boy in no acute distress.  The tympanic membranes are not erythematous; mucous membranes are moist; and tonsils are enlarged and erythematous with white exudate.  S1 and S2 are normal without murmurs.  The lungs are clear to auscultation bilaterally.  Lymphadenopathy is present in the anterior cervical, posterior cervical, axillary, and inguinal chains.  The abdomen is soft and nontender.  Laboratory results are as follows:   The peripheral blood smear is shown in the image:   What is the most likely reason for these findings? A) Hematologic malignancy B) Lymphoproliferative malignancy C) Parasitic infection D) Systemic bacterial infection E) Systemic viral infection

A 15-year-old boy is brought to the office due to fever. He has had fever, chills, fatigue, and myalgias for the past 10 days. He has lost some weight, which was attributed to poor appetite. Three weeks ago, the patient and his family returned from a trip to the Dominican Republic; he has not traveled anywhere else. There are no sick contacts at home. The patient has no significant medical history and takes no medications. Temperature is 38.3 C (101 F) , blood pressure is 110/60 mm Hg, and pulse is 108/min. Physical examination shows a tired-looking boy in no acute distress. The tympanic membranes are not erythematous; mucous membranes are moist; and tonsils are enlarged and erythematous with white exudate. S1 and S2 are normal without murmurs. The lungs are clear to auscultation bilaterally. Lymphadenopathy is present in the anterior cervical, posterior cervical, axillary, and inguinal chains. The abdomen is soft and nontender. Laboratory results are as follows:  The peripheral blood smear is shown in the image:
The peripheral blood smear is shown in the image: What is the most likely reason for these findings?
What is the most likely reason for these findings?
A) Hematologic malignancy
B) Lymphoproliferative malignancy
C) Parasitic infection
D) Systemic bacterial infection
E) Systemic viral infection
Correct Answer:
Verified
Q324: A 64-year-old woman with a known history
Q325: A 5-year-old boy is brought to the
Q326: A 65-year-old man comes to the office
Q327: A 45-year-old man comes to the emergency
Q328: A newborn boy is being evaluated in
Q330: A 45-year-old female presents to your office
Q332: A 26-year-old woman phones after business hours
Q333: A 65-year-old man comes to the office
Q334: A 35-year-old woman comes to the office
Q1291: A 57-year-old man who just returned from
Unlock this Answer For Free Now!
View this answer and more for free by performing one of the following actions

Scan the QR code to install the App and get 2 free unlocks

Unlock quizzes for free by uploading documents